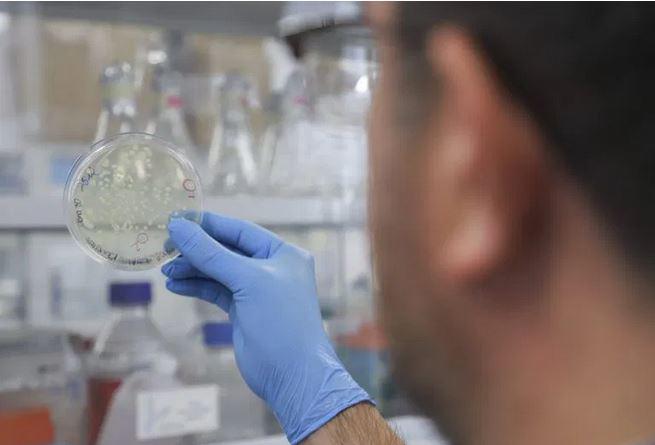
$!La Universidad Autónoma de Querétaro desarrolla desde el año pasado su vacuna anti Covid QUIVAX. Foto: Cortesía UAQ.

Hay 6 proyectos mexicanos de vacuna contra el Covid-19; 3 avanzados. Pero no hay dinero
MÉXICO._ A un año de que la Organización Mundial de la Salud (OMS) declarara la pandemia del Covid-19, la carrera por el desarrollo de vacunas no ha parado y cada día se suman nuevos proyectos. A nivel mundial, por ejemplo, hay 81 candidatas en desarrollo clínico y 182 en fase preclínica, además de los tres antígenos rusos.
En el caso de México, hay seis proyectos encabezados por universidades que sortean con bajo presupuesto este arduo camino, de los cuales solo tres podrían dar vacunas a fin de año.
Estos proyectos, que están en fase preclínica debido a los pocos recursos e infraestructura que tienen los laboratorios de las instituciones académicas del país, son: la basada en el virus de la enfermedad de Newcastle (Laboratorios Avimex, el IMSS, Cinvestav y la UNAM); de Nanoplásmidos npJS19 (IPN, Instituto Tecnológico y de Estudios Superiores de Monterrey y Universidad de Baja California; por despliegue de epítopos (Instituto de Biotecnología de la UNAM); de quimera recombatiente multiepitópica (Universidad Autónoma de Querétaro; de Péptidos sintéticos (Grupo Neolpharma y el Instituto de Investigaciones Biomédicas de la UNAM), y la vacuna de la Universidad Michoacana de San Nicolás de Hidalgo.
Los cinco primeros proyectos han recibido un apoyo económico por parte de la Secretaría de Relaciones Exteriores (SRE), mientras que el de la Universidad Michoacana de San Nicolás de Hidalgo (UMSNH) ha subsistido con sus propios recursos, por lo que aún les faltan millones de pesos para concluir la etapa preclínica, contaron a SinEmbargo los investigadores que encabezan las tres candidatas a vacunas mexicanas más avanzadas: la de la UNAM, la de la UAQ y la de la UMSNH.
“No estamos caminando de la mano para resolver los problemas del país. México era líder en producción de vacunas hace 70 años, exportábamos vacunas, pero toda esa industria se desmanteló en los años 90, ya no existe y lo poco que existe está atomizado en algunas universidades y centros de investigación. Creo que ahora es el momento para demostrar que se puede confiar en la ciencia y el talento mexicano porque tenemos con qué, lo que necesitamos es el apoyo de los gobiernos”, dijo en entrevista la doctora Teresa García Gasca, Rectora de la Universidad Autónoma de Querétaro.
Estos proyectos comenzaron a desarrollarse desde el año pasado, aunque la falta de recursos han detenido sus avances, por lo que instituciones como la Universidad Autónoma de Querétaro realizan esfuerzos a través de un “vacunatón” para concluir este 2021 su fármaco llamado QUIVAX.
Las otras dos candidatas también van por buen camino: la UMSNH ya está en pláticas con un laboratorio mexicano y otro extranjero para el desarrollo de su Fase 1, mientras que uno de los dos proyectos que tiene la UNAM, el encabezado por los doctores Edda Sciutto y Juan Pedro Laclette, del Instituto de Investigaciones Biomédicas (IIBm), trabaja de la mano con los Laboratorios Alpharma.
A mediados de febrero, el Presidente Andrés Manuel López Obrador destacó el proceso de investigación de las vacunas “Soberana 01” y “Soberana 02” que desarrolla Cuba y señaló que en México también se llevan a cabo proyectos para generar una vacuna, que sugirió se llame “Patria”. De los tres antígenos más avanzados en el país ninguno lleva este nombre, pero aún faltan conocer detalles de los otros tres, más los que se sumen.
México fue uno de los primeros en iniciar la vacunación contra la Covid-19 el 24 de diciembre pasado con el fármaco de Pfizer y BioNTech, pero hasta el corte del 14 de marzo solo se habían aplicado 4 millones 214 mil 494 dosis. En el país se tienen registrados cerca de 200 mil muertos y más de 2 millones de casos confirmados de esta enfermedad.
Hasta el mes de marzo, el Gobierno mexicano había precomprado 34.4 millones de dosis de Pfizer, 79.4 millones de la británica AstraZeneca, 35 millones de la china CanSino, 24 de la rusa Sputnik V, 22 millones de las farmacéuticas chinas Sinovac y Sinopharm, y 51.4 millones de la plataforma Covax de la Organización Mundial de la Salud (OMS).
Estas son las tres vacunas mexicanas que podrían estar listas a finales de este año:
La QUIVAX de la Universidad de Querétaro
La Universidad Autónoma de Querétaro (UAQ), que convocó el próximo 27 de marzo a un “vacunatón” para reunir donativos y continuar con el desarrollo de su fármaco QUIVAX, inició con su proyecto el año pasado. La característica de su vacuna es que es proteíca, es decir, es una proteína que diseñaron a partir de seis fragmentos que conforman la espícula viral del coronavirus.
“Este virus tiene una corona, de ahí su nombre de coronavirus y esta corona está formada por estas espículas. De esas espículas nosotros tomamos seis fragmentos y generamos una nueva proteína que no existe como tal en la naturaleza”, explicó en entrevista la doctora Teresa García Gazca, Rectora de la Universidad Autónoma de Querétaro.
Cada fragmento, agregó la Rectora, es capaz de generar su propia producción de anticuerpos.
“Ya la hemos probado en animales experimentales con muy buenos resultados y con buenos signos de seguridad, es decir, los animales no muestran sintomatología grave, un poco de fiebre, pero nada que nos alerte”.

Todo este proceso lo han realizado en los laboratorios de la Universidad Autónoma de Querétaro con fondos de la propia casa de estudios, donativos y un recurso semilla que les proporcionó la SRE de 3.3 millones de pesos.
Hasta el momento han gastado ocho millones de pesos, pero aún necesitan 20 millones más para terminar la etapa preclínica y las fases 1 y 2.
“Ya con todo este paquete se evalúa nuestra vacuna y se decide si pasamos a Fase 3, que nosotros creemos que sí”, mencionó la doctora Teresa García Gasca.

El equipo que desarrolla esta vacuna, el cual está encabezado por el doctor Juan Joel Mosqueda, hizo un llamado a los mexicanos a participar en el “vacunatón” del día 27 de marzo, el cual será un evento artístico que comenzará a las 10:00 y concluirá a las 18:00 horas.
“Nosotros seguimos trabajando y para poder continuar necesitamos las pruebas preclínicas en roedores, pero ya estas pruebas las tenemos que hacer en laboratorios certificados, principalmente las pruebas de desafío que consisten en probar que la vacuna realmente protege a animales, es decir, son pruebas más especializadas”, destacó la Rectora de la UAQ.
La ingeniera Bioquímica Industrial con posgrado en Ciencia de los Alimentos llamó a las autoridades para apoyar los seis proyectos mexicanos.
“Nosotros hemos estado tocando puertas en Conacyt, en la Secretaría de Salud federal y la de Querétaro, pero sin resultados”, aseguró. “Todos son de excelente calidad, los seis deben ser apoyados, debemos todos llegar a fase 2 y que México tenga una vacuna excelente”.

La UNAM-AP-rP9, de la UNAM
En la Universidad Nacional Autónoma de México (UNAM) hay dos candidatas de vacuna, una a cargo de la doctora Laura Palomares del Instituto de Biotecnología y la segunda encabezada por los doctores Edda Sciutto y Juan Pedro Laclettes, del Instituto de Investigaciones Biomédicas.
En este último proyecto participa una red de investigadores del departamento de Inmunología del Instituto de Investigaciones Biomédicas y de otras disciplinas como Biología Molecular, Medicina, además de instituciones como el Cinvestav y la Universidad Autónoma de San Luis Potosí y los Laboratorios Alpharma.
“Desde el principio nuestra vacuna surgió en asociación con una empresa que se llama Laboratorios Alpharma y por eso una de las virtudes de nuestra vacuna es que todas las pruebas que se han hecho han sido realizadas con material que ya ha producido la planta industrial. Es decir, nosotros ya no tenemos que transferir esa tecnología porque ya está en la planta”, dijo en entrevista el doctor Juan Pedro Laclette.

El desarrollo de esta vacuna comenzó desde marzo del año pasado con una investigación de la proteína que todos los candidatos vacunales han utilizado, que es la proteína espiga o la proteína S.
“Nosotros hicimos un análisis inmunológico y diseñamos seis regiones de esa proteína y esos se probaron inmunológicamente en animales de laboratorio durante varios meses hasta que los resultados nos hicieron ver que había una región de esa proteína que era la más importante y a partir de ahí hemos expandido esa región, la hemos complementado con nuestros propios resultados”, detalló el doctor Lanclette.
Esta vacuna, agregó el investigador de la UNAM, tiene la gran virtud de poder adaptar una secuencia a las nuevas variantes que se vayan presentando, como las que han surgido en los últimos meses en Gran Bretaña, Brasil y Sudáfrica, que son entre 30 y 50 por ciento más contagiosas.
La vacuna de la UNAM, que comenzará las pruebas clínicas en seres humanos en el mes de abril para que quede lista a finales de este año, tiene dos posibles nombres: “IIB-AP-rP9” o “UNAM-AP-rP9”, y su costo al mercado será bajo en comparación con las vacunas de vectores virales, mencionó el doctor Laclette.

Otra ventaja de esta vacuna es que no requiere red de ultrafrío y se puede distribuir a través de la red normal que se utiliza en el Gobierno para las campañas de vacunación. Al igual que en varias de las vacunas existentes, se necesitarían dos dosis de aplicación porque hay que dar un refuerzo.
Esta candidata de vacuna anti Covid recibió un primer apoyo por parte de la UNAM y después la SRE les otorgó recursos a través de la Agencia Mexicana de Cooperación Internacional para el Desarrollo (AMEXCID).
Hasta el momento han gastado alrededor de 15 millones de pesos, contando salarios de investigadores, materiales y reactivos.
“Si lo comparas con lo que el Gobierno de Estados Unidos le otorgó a Pfizer, que fue un billón de dólares (20 mil millones de pesos), pues es muy poco, menos de una milésima parte”, enfatizó el doctor de la UNAM. “Nuestro desarrollo ha tenido un costo moderado gracias a la confluencia de los esfuerzos entre investigadores, instituciones de educación superior, una empresa y las autoridades”.

La vacuna de la Universidad Michoacana de San Nicolás de Hidalgo
La vacuna que desarrolla la UMSNH, que aún no tiene nombre, es de “mosaico”, es decir, que está constituida de varias proteínas del virus, lo que en un algún momento puede asegurar una respuesta inmune potente al momento de aplicar la vacuna.
“Es una vacuna más tradicional que la de RNA o DNA, como son las de Pfizer, AstraZeneca y Sputnik, y por lo mismo tampoco necesita la cadena de frío que requiere la distribución de esas vacunas mencionadas”, explicó el profesor investigador del Centro Multidisciplinario de Estudios de Biotecnología de la Facultad Medicina Veterinaria de la UMSNH, Alejandro Bravo Patiño.

El antígeno, que desde hace un año desarrolla la universidad, está en la etapa dos de la experimentación, es decir, se están armando los primeros mosaicos que permitirán hacer las pruebas para ver cómo responde el sistema inmune en los animales de experimentación y partir de ahí se hará la selección definitiva para tener un prototipo a finales de este año.
El investigador de la Universidad Michoacana de San Nicolás de Hidalgo contó a SinEmbargo que a finales de 2019, cuando China dio la señal de alarma, el Rector consultó con un equipo de investigadores para que estuvieran preparados por el nuevo virus SARS-CoV-2.

“El equipo de trabajo ya tenía dos plataformas sólidas en cuanto a investigación porque veníamos haciendo trabajos con biosensores para detectar los virus y desarrollar vacunas para otros virus que atacan el sistema respiratorio de los animales, esto nos permitió hacer la reactivación rápida de la plataforma y adaptarlas al SARS-CoV-2”, dijo el profesor Alejandro Bravo Patiño.
Sobre los recursos para este proyecto, el investigador del Centro Multidisciplinario de Estudios de Biotecnología recordó que fueron evaluados por el Conacyt, pero ya no alcanzaron dinero en cuanto al techo financiero. Sin embargo el Rector tomó la decisión de apoyarlos.

“El Gobierno aún no nos ha dado recursos, hasta ahora vamos trabajando con recursos propios de la universidad y de otros proyectos que nosotros hemos desarrollado, pero vamos a llegar a un punto en el que sí los necesitemos porque tendremos que hacer los escalamientos industriales y pruebas clínicas que son muy caras”, reconoció el investigador. “Son protocolos internacionales que debemos de seguir para asegurar un producto de buena calidad y para esas etapas sí vamos a necesitar apoyos del Gobierno y de compañías farmacéuticas”.
Las cantidades de dinero, agregó, “son exorbitantes y eso solo lo vamos a lograr o con el apoyo del Gobierno o aliándonos con una compañía farmacéutica que ya sabe estos procesos para lograr la autorización, la propia Cofepris exige la asociación con una farmacéutica”.

Actualmente se encuentran en pláticas con dos farmacéuticas, una nacional y otra extranjera.
El equipo que desarrolla la vacuna de la Universidad Michoacana de San Nicolás de Hidalgo está conformado por cuatro profesores investigadores, seis estudiantes de posgrado y otros cuatro de licenciatura, además de tres técnicos.





